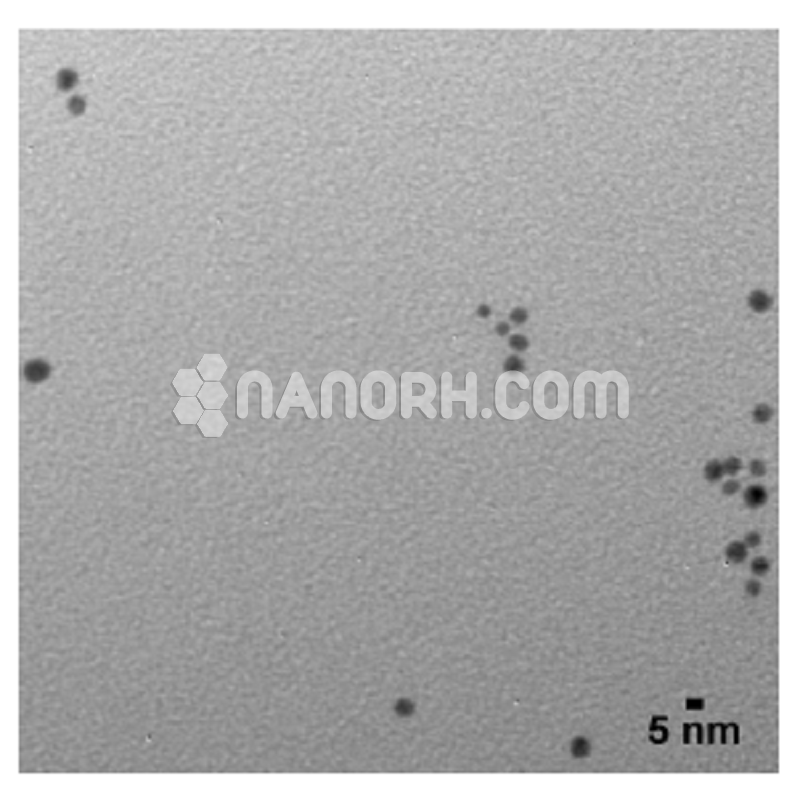
Nano Silver Fluoride Chitosan Stabilized Nano Silver Fluoride Chitosan Stabilized

Nano Silver Fluoride Chitosan Stabilized
This product is a very stable complex silver solution with ultra-small nano-particles, has a very good anti-bacterial and anti-yellowing properties. The product is for research purpose! (To dilute it to your desired concentration, only add pure water and shake it up!)
| Nano Silver Fluoride Chitosan Stabilized | |
| Product No | NRE-22032 |
| CAS No. | 7775-41-9 |
| Formula | AgF |
| Molecular Weight | 126.866 g/mol |
| APS | <80nm (can be customized) |
| Purity | 99.99% |
| Color | Brown/black |
| Form | Liquid |
| Concentration | 200ppm (Can be Customized) |
| Solvent | Water (As per requirement) |
| Stabilizing agent | Chitosan |
Nano Silver Fluoride Chitosan Stabilized is a promising anticaries agent that has been proven to be an antimicrobial agent similar to SDF, with low toxicity to living cells and the potential advantage of not staining teeth black.
Nano Silver Fluoride Chitosan Stabilized -The antibacterial mechanism of silver nanoparticles (AgNPs) relies on their ability to penetrate the bacterial cell wall and cause direct and indirect lipidic peroxidation,
which damages the cell membrane, disrupts the DNA replication and repair, and inhibits respiratory proteins.
Silver (Ag) Nanoparticles Aqueous Dispersion Applications:
Various antibacterial finishing for textiles, paper products, leather, and the sponge; anti-bacterial deodorant treatment for all kinds of footwear, toys, and daily necessities; used to implement anti-bacterial deodorizing for a variety of water-based and oil-based paints; widely used in the medical field: microbicides, antibacterial gel, lotion, and tablets.